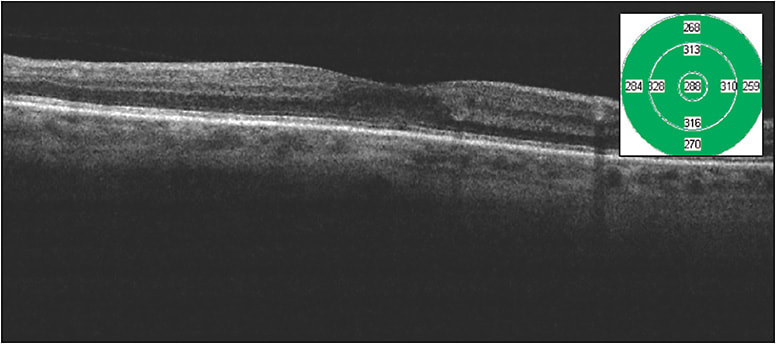
Figure 2. Spectral-domain optical coherence tomography 2 months after micropulse laser therapy in a 67-year-old white female who presented with moderate nonproliferative diabetic retinopathy and foveal involving macular edema with excellent vision. Imaging shows improved macular edema with central foveal thickness of 288 µm.

Micropulse laser therapy was gaining ground prior to the advent of anti-VEGF therapy. Although it may feel like a recent development, Friberg and Venkatesh first described a technique of microsecond laser diode pulses meant to reduce pain with photocoagulation in 1995.1 The goal was to apply the same final laser fluence as a continuous-wave application but with microsecond breaks in the pulse. Then, in 1997, Friberg and Karatza described the efficacy of micropulsed 810-nm wavelength photocoagulation in branch retinal vein occlusion and diabetic macular edema (DME).2 The recognition that this modality resulted in tissue cooling during the treatment pulse with a resultant lack of visible endpoint (during treatment and at any time after treatment) was at once advantageous and disconcerting. Can we effectively address underlying endothelial and metabolic dysfunction without creating visually disabling scotoma? Without a visible endpoint, how can we be sure that we have reached the ideal zone of a therapeutic effect without overtreating or undertreating? Histologic and electron microscopy evaluations show that the reduced microsecond pulsing would increase retinal pigment epithelium (RPE) thermal energy without denaturing protein, hence sparing the neural retina.3-5 This RPE irritation has been shown to induce heat shock protein expression in RPE cells with repair of the inner blood retinal barrier.6-8 Ancillary testing with spectral-domain optical coherence tomography, fluorescein angiography, microperimetry, and fundus autofluorescence also have not revealed gross clinical evidence of anatomic alterations.9,10
STUDIES OF MICROPULSE
When considering clinical evidence and functional outcomes, the literature is rife with small, retrospective case series with visual outcomes equivalent or superior to traditional continuous wave photocoagulation in DME.11-13 Several small prospective trials are ongoing as well. A 2018 Cochrane review concluded that subthreshold, or laser treatment without a visible endpoint, photocoagulation may be as effective as standard photocoagulation based on currently available data.14 To investigate this, our group analyzed the first 100 eyes with DME treated at our practice with micropulse laser monotherapy, using the Iridex IQ 532 laser system in its MicroPulse mode, without adjuvant pharmacotherapy. We found a statistically significant improvement in central foveal thickness (CFT) from 343 µm to 325 µm (P=.03) with stable visual acuity of 20/41 to 20/39 (P=.37). One interesting subanalysis revealed that if split in the middle, the first 50 eyes had a reduction in CFT from 341 to 327, while the second 50 eyes improved from 348 µm to 321 µm, a doubling of the therapeutic effect. This learning curve may speak to the difference between treatment failure and treater failure. At this time, there is no standardized micropulse protocol, and early attempts may thusly fail. As we honed our settings, increased the spot density and count, and became more comfortable with treating perifoveally, our outcomes improved. As discussed above, micropulse laser therapy alters RPE metabolism and enhances endothelial healing and does not work on the principle of transretinal photothermic injury and coagulation, thus we should not use the same treatment design for micropulse laser as we would for continuous-wave laser.
CASE EXAMPLE
Figures 1 and 2 show images of a patient with moderate nonproliferative diabetic retinopathy and foveal-involving macular edema with excellent vision. It is difficult in my treatment discussions to march down the anti-VEGF path for these patients, because they are asymptomatic and often in the workforce, and I am unable to provide them an accurate prediction of the number of injections needed to achieve anatomic success. This patient received a single micropulse laser treatment and improved from a CFT of 318 µm to 288 µm with a visual acuity improvement from Snellen 20/30 to 20/25 over 2 months. This is a very good outcome for patients such as this.

Micropulse technology is available in 810 nm, 577 nm, and 532 nm wavelengths. There are nuances to each wavelength (Table 1), but the decision of which wavelength to use will often come down to surgeon preference and cost.
| 810 nm | 577 nm | 532 nm | |
|---|---|---|---|
| Maximal Absorption | Retinal pigment epithelium | Melanin, oxyhemoglobin | Melanin, hemoglobin, oxyhemoglobin |
| Minimal Absorption | Media opacity, luteal pigment, hemorrhage | Xanthophyll | Xanthophyll |
| Features | Not attenuated by thickened neurosensory retina | Minimal spot expansion | Most widely used laser wavelength (including surgical) |
We use the Iridex IQ 532 laser, because we are most familiar with the response of 532 nm burns in the office and in the operating room. The 810-nm diode wavelength has advantages in several regards, including laser penetration depth and ability to overcome media opacity and hemorrhage; thus, the 810-nm wavelength may be superior in primarily choroidal pathologies such as central serous chorioretinopathy and age-related macular degeneration, among others. However, significant patient discomfort is reported using standard continuous-wave photocoagulation due to higher power requirements, hence traditional pathologies requiring laser photocoagulation including retinal tears and panretinal photocoagulation may be challenging without periocular anesthesia. The 577-nm laser may serve as an excellent intermediate choice in regards to penetration, subjective discomfort, and predictable laser spot size. The minimal xanthophyllic absorption also allows for micropulse laser to be applied closer to, and even over, the fovea.
The lack of clear treatment parameters can make adoption of micropulse laser therapy challenging in the beginning. But human disease is neither uniform nor static, and application of a single treatment paradigm is likely to result in suboptimal outcomes. There is an expected learning curve using micropulse technology, because retina specialists may apply previously learned laser techniques, undertreating and staying well away from the fovea. With continued use and surgeon comfort, the results can improve. Patient selection is also important, because micropulse laser therapy is not a panacea. There are some eyes that are simply not amenable to any treatment, whether it is anti-VEGF, steroid, or micropulse, and attributing it to micropulse failure may be unjust.
My treatment parameters are what I feel to be the ideal blend of safety and efficacy for 532-nm wavelength micropulse laser treatment. First, I always apply a traditional continuous-wave titration spot for 2 reasons: 532-nm wavelength is melanin dependent and the treatment fluence will vary greatly on ocular pigmentation, thus I do not want to overtreat a darkly pigmented fundus. Also, if there is a hardware issue, such as fiberoptic kink and breakage, then the treatment power (mW) to achieve a traditional laser spot will be higher than expected, resulting in undertreatment in micropulse mode.
The only variable I adjust after achieving my expected titration burn is power. Based on the fluence equation calculation, spot area is squared and thus logarithmically variable, so spot size should ideally not be adjusted after the titration spot. I start at 50 mW of power at 200 ms duration with a 200-µm spot size. Once I achieve the gray burn of a standard focal laser spot outside of the area of edema, I switch from continuous-wave mode to micropulse mode at 5% duty cycle and multiply by 3 up to a maximum of 400 mW of power. For example, if the standard focal spot is achieved at 100 mW power, I will deliver micropulse laser therapy at 5% duty cycle at 300 mW power. If the standard spot is achieved at 150 mW power, I will treat at 5% duty cycle at 400 mW of power. Duty cycle refers to the on and off cycles of micropulse technology. In a single envelope of laser treatment, the on and off cycles are pulsed, and the 5% ratio refers to the amount of time the laser is set to on relative to the treatment envelope. 5% duty cycle would theoretically be safer than 50% duty cycle, and histologic safety has been established as described above.
INDUCING METABOLIC CHANGE
An important characteristic of micropulse laser therapy is its ability to induce metabolic change in the RPE and vascular endothelium, thus sparse, isolated points of laser will be subtherapeutic. The number of therapeutic micropulse spots should count in the hundreds. The spots should ideally be touching, at a minimum, or even slightly overlapping. The Iridex scanning pattern laser delivery system set at 0 spacing allows for ease of application. For DME, I treat the entire area of edema and extend beyond the edema for at least 2 laser spot widths. I also apply traditional continuous-wave focal laser to any obvious extrafoveal leaking microaneurysms. For branch retinal vein occlusion, I use fluorescein angiography to guide micropulse treatment to all areas of capillary nonperfusion, including subfoveally and extending peripherally as far as possible.
For central serous chorioretinopathy, the underlying pathology is not from leaking microaneurysms or capillary nonperfusion, but from diffuse vascular leakage, thus panmacular treatment may be necessary. If a focal hot spot is the causative lesion for the central serous chorioretinopathy, then focal continuous-wave laser photocoagulation can suffice. Micropulse laser therapy has been described in the treatment or alleviation of treatment burden for other conditions as well, including age-related macular degeneration, macular telangiectasia, radiation retinopathy, proliferative diabetic retinopathy, among others, and I look forward to larger, prospective trials evaluating micropulse for these conditions. Lastly, I use a Mainster digital centralis as my contact lens of choice, with 1.06x magnification and a wider field of view (70°/84°) than traditional focal lenses for ease of diffuse macular treatment area.
CONCLUSION
Micropulse laser therapy is transformative in its own right, but it reached prominence at a time when anti-VEGF stepped into the forefront. Micropulse technology and anti-VEGF may be related in our armamentarium of vascular retinopathies but they are not the same, and it may be worth a revisit to micropulse laser therapy. RP
REFERENCES
- Friberg TR, Venkatesh S. Alterations of pulse configuration affects the pain response during diode laser photocoagulation. Lasers Surg Med. 1995;16(4):380-383.
- Friberg TR, Karatza EC. The treatment of macular disease using a micropulsed and continuous wave 810-nm diode laser. Ophthalmology. 1997;104(12):2030-2038.
- Scholz P, Altay L, Fauser S. A review of subthreshold micropulse laser for treatment of macular disorders. Adv Ther. 2017;34(7):1528-1555.
- Sivaprasad S, Elagouz M, McHugh D, Shona O, Dorin G. Micropulsed diode laser therapy: evolution and clinical applications. Surv Ophthalmol. 2010;55(6):516-530.
- Wells-Gray E, Doble N, Ohr M, Choi SS. Structural integrity of individual cone photoreceptors after short-wavelength subthreshold micropulse laser therapy for diabetic macular edema. Ophthalmic Surg Lasers Imaging Retina. 2018;49(12):946-954.
- Inagaki K, Shuo T, Katakura K Ebihara N, Murakami A, Ohkoshi K. Sublethal photothermal stimulation with a micropulse laser induces heat shock protein expression in ARPE-19 cells. J Ophthalmol. 2015:729-792.
- Dorin G. Evolution of retinal laser therapy: minimum intensity photocoagulation (MIP). Can the laser heal the retina without harming it? Semin Ophthalmol 2004;19(1-2):62-68.
- Yu A, Merrill K, Truong S, Forward KM, Morse LS, Telander DG. The comparative histologic effects of subthreshold 532- and 810-nm diode micropulse laser on the retina. Invest Ophthalmol Vis Sci. 2013;54(3):2216-2224.
- Vujosevic S, Bottega E, Casciano M, Pilotto E, Convento E, Midena E. Microperimetry and fundus autofluorescence in diabetic macular edema: subthreshold micropulse diode laser versus modified early treatment diabetic retinopathy study laser photocoagulation. Retina. 2010;30(6):908-916.
- Vujosevic S, Martini F, Longhin E, Cavarzeran F, Convento E, Midena E. Subthreshold micropulse yellow laser versus subthreshold micropulse infrared laser in center-involving diabetic macular edema. Retina. 2015;35(8):1594-1603.
- Lavinsky D, Cardillo JA, Melo LA Jr, Dare A, Farah ME, Belfort R Jr. Randomized clinical trial evaluating mETDRS versus normal or high-density micropulse photocoagulation for diabetic macular edema. Invest Ophthalmol Vis Sci. 2011;52(7):4314-4323.
- Kumar V, Ghosh B, Mehta DK, Goel N. Functional outcome of subthreshold versus threshold diode laser photocoagulation in diabetic macular oedema. Eye (Lond). 2010;24(9):1459-1465.
- Chen G, Tzekov R, Li W, Jiang F, Mao S, Tong Y. Subthreshold micropulse diode laser versus conventional laser photocoagulation for diabetic macular edema: a meta-analysis of randomized controlled trials. Retina. 2016;36(11):2059-2065.
- Jorge EC, Jorge EN, Botelho M, Farat JG, Virgili G, El Dib R. Monotherapy laser photocoagulation for diabetic macular oedema. Cochrane Database System Rev. 2018;10:CD010859.








